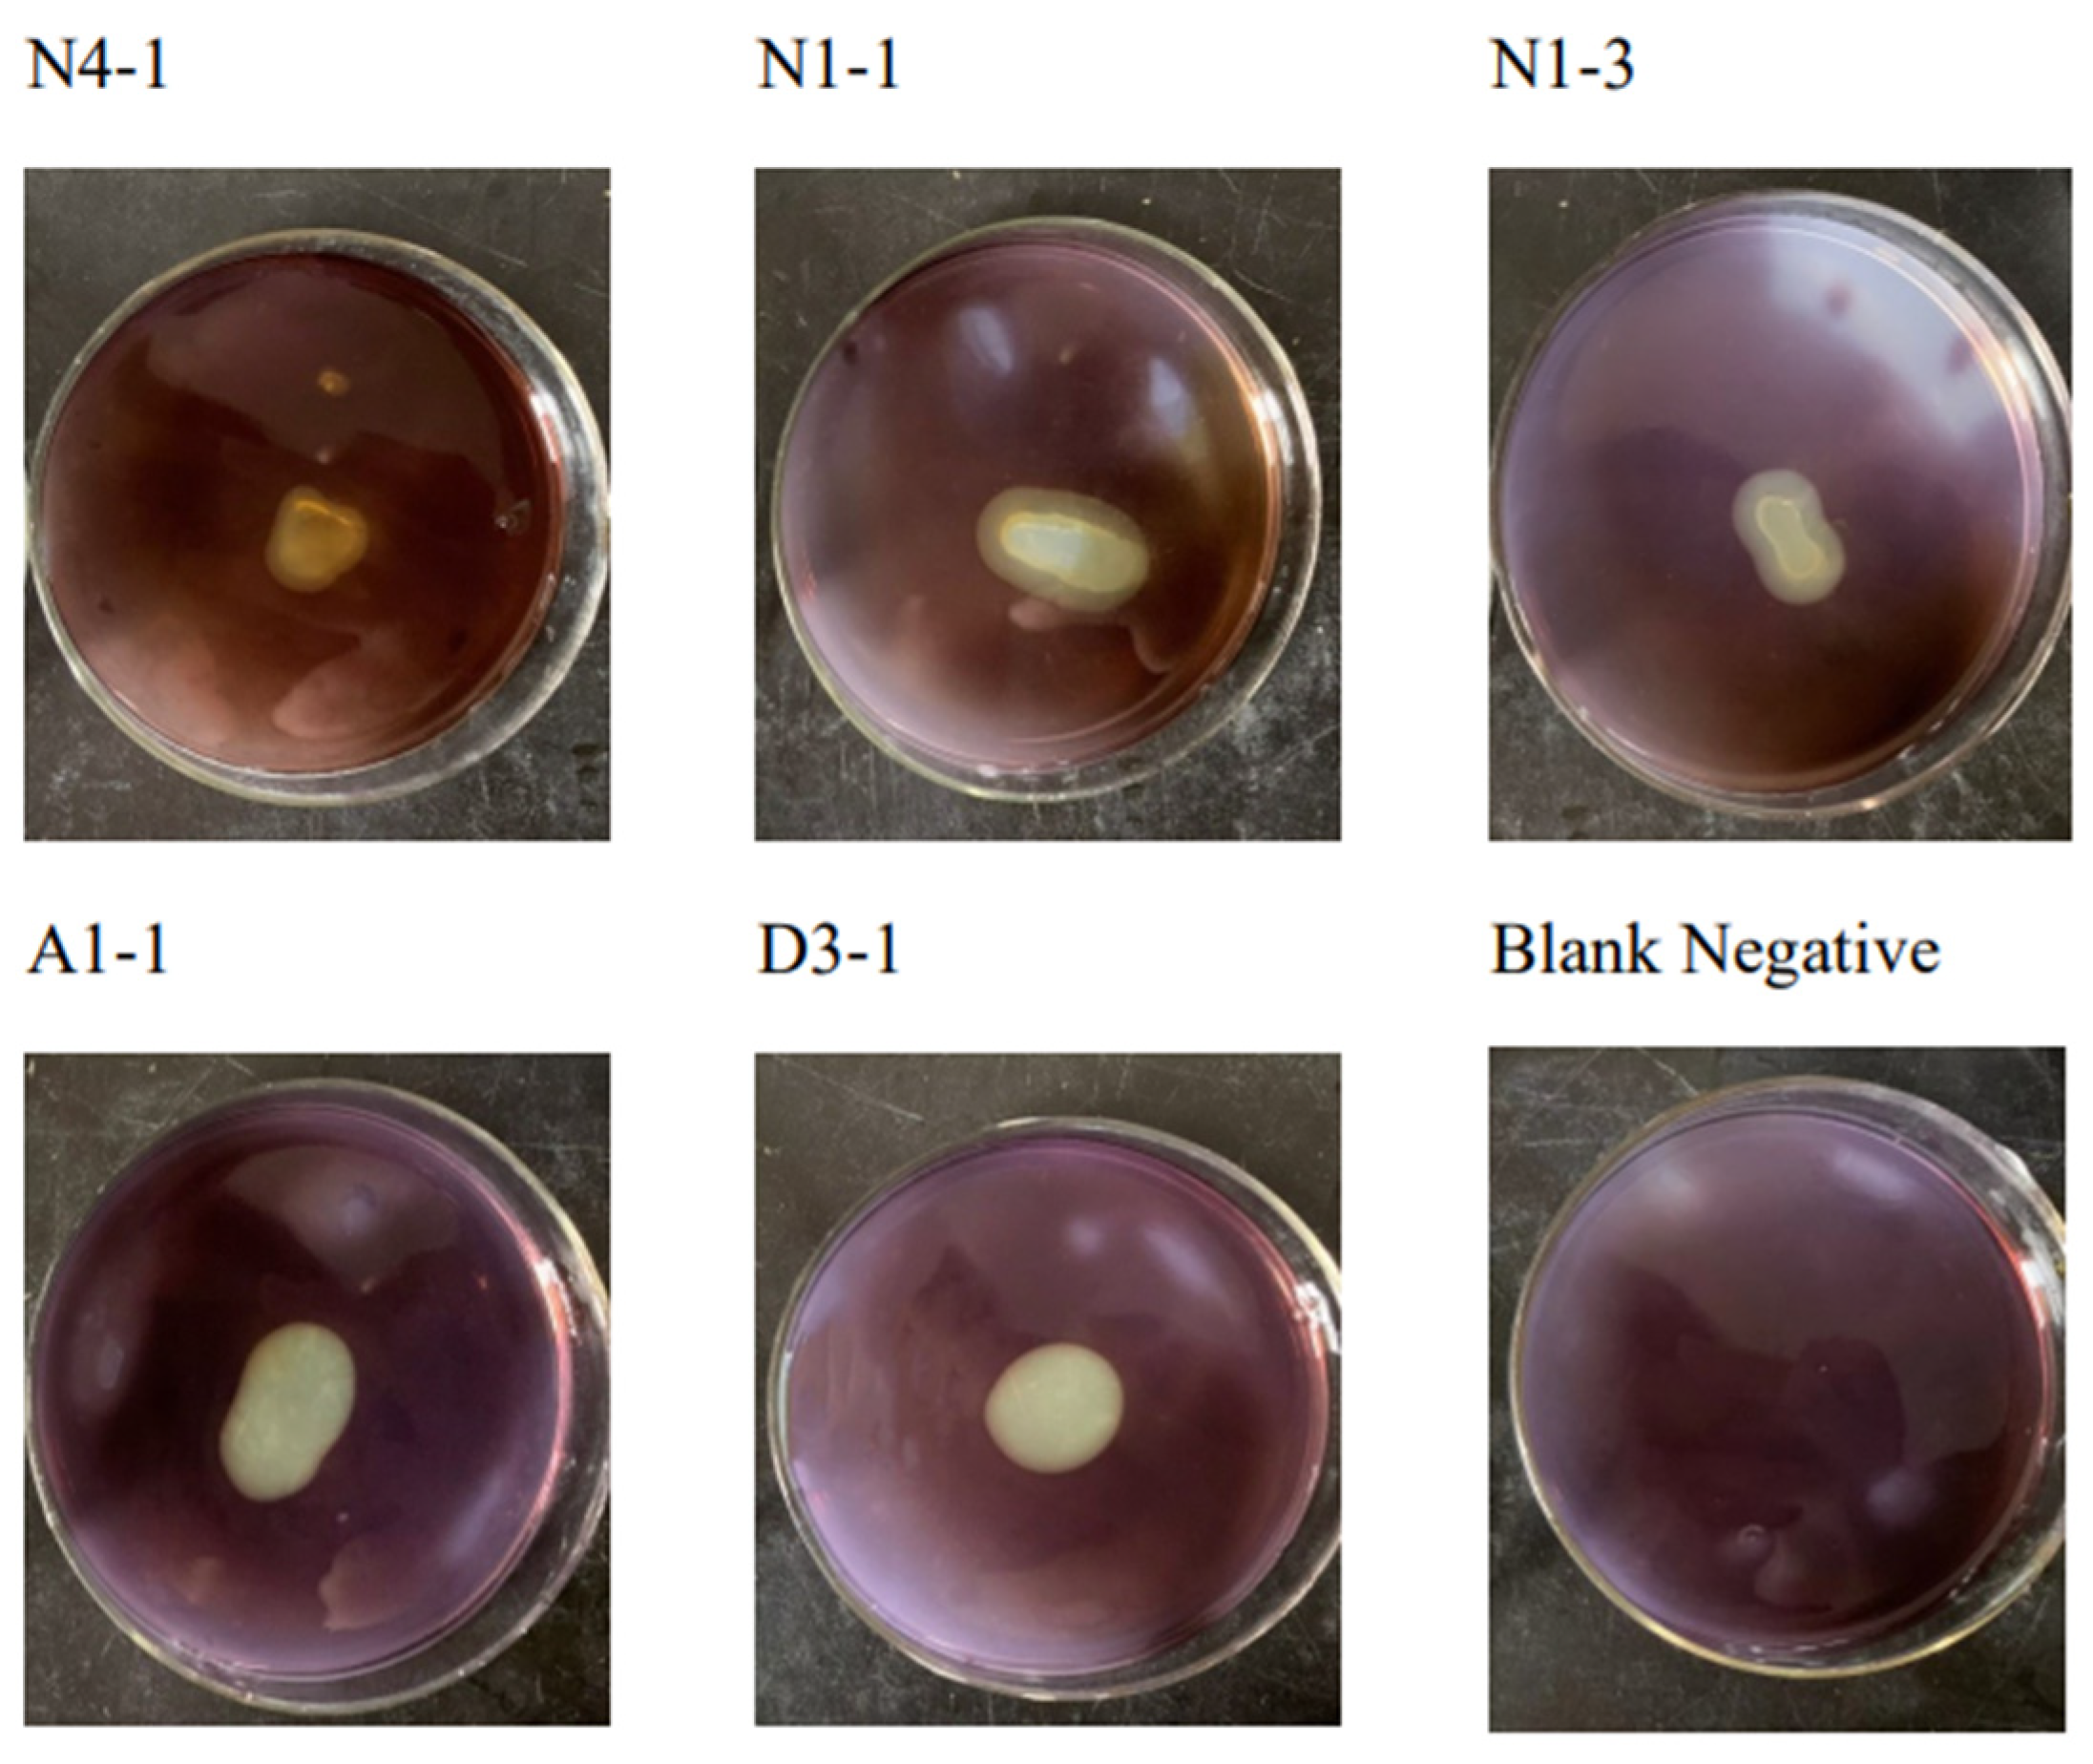
Water 17 02225 g002

The Optimization of Culture Conditions for the Cellulase Production of a Thermostable Cellulose-Degrading Bacterial Strain and Its Application in Environmental Sewage Treatment
Abstract
1. Introduction
2. Materials and Methods
2.1. Sample Sources and Culture Media
- (A)
- R2A agar (g L−1) contained 0.5 g yeast extract, 0.5 g peptone, 0.5 g starch, 0.5 g MnSO4, 0.5 g casein hydrolysate, 0.5 g glucose, 0.3 g K2HPO4, 0.3 g sodium pyruvate, 15 g agar, and distilled water to 1 L total volume.
- (B)
- LB broth (g L−1) contained 10 g peptone, 5 g yeast extract, 5 g NaCl, and distilled water to 1 L total volume.
- (C)
- CMC agar (g L−1) contained 5 g CMC, 1 g NaNO3, 1 g K2HPO4, 1 g NaCl, 0.5 g MgSO4, 0.5 g yeast extract, 15 g agar, and distilled water to 1 L total volume.
- (D)
- Cellulase production broth (g L−1) contained 10 g CMC, 10 g peptone, 7.5 mg FeSO4·7H2O, 2.5 mg MnSO4·H2O, 2.0 mg ZnSO4, and distilled water to 1 L total volume.
- (E)
- Basal culture medium (g L−1) [19] contained 0.5 g CaCl2·2H2O, 0.4 g FeSO4·7H2O, 1 g K2HPO4, 0.05 g MgSO4·7H2O, 2 g NaCl, 1.5 g NaHCO3, 1 mL trace element solution, and distilled water to 1 L total volume.
- (F)
- The denitrification medium (simulated sewage) contained 0.324 g L−1 KNO3, added to the basal medium as the only nitrogen source; the carbon source was added separately as an experimental variable.
2.2. Screening, Isolation, and Identification
2.3. Quantification of Cellulase Activity
2.4. Single-Factor Optimization of Cellulase Production Conditions
2.5. Optimization of Cellulase Production Through Response Surface Methodology
2.6. Product Analysis of Maize Straw Flour Degradation by Strain D3-1
2.7. Denitrification Application of Degradation by Strain D3-1 with Carbon Source
2.7.1. The Denitrification Performance of Different Bacterial Agents in Simulated Sewage Under Different Carbon Sources
2.7.2. The Design of Denitrification Performance of MSFDL as a Carbon Source in Municipal Sewage
3. Results
3.1. Screening and Identification
3.2. Molecular Identification of the Cellulase-Producing Strain
3.3. Preliminary Single-Factor Experiments
3.4. The Cellulase Production Conditions of D3-1 Were Optimized Using Response Surface Methodology (RSM)
3.4.1. Analysis of Variance (ANOVA)
3.4.2. Optimization of Cellulase Production
3.5. Product Analysis of Maize Straw Degradation by Strain D3-1
3.6. Denitrification Application Results
3.6.1. The Denitrification Performance of Different Bacterial Agents in Simulated Sewage with Different Carbon Sources
3.6.2. The Denitrification Performance of MSFDL as a Carbon Source in Municipal Sewage
- (1)
- The nitrogen removal effects in municipal sewage for 4 h under different carbon sources are as follows:
- (2)
- The nitrogen removal effects in municipal sewage for 72 h under different carbon sources are as follows:
4. Conclusions and Discussion
Author Contributions
Funding
Data Availability Statement
Acknowledgments
Conflicts of Interest
Abbreviations
| GC-MS | Gas Chromatography–Mass Spectrometry |
| MSFDL | Maize Straw Flour Degradation Liquid |
| C/N | Carbon/Nitrogen |
| TN | Total Nitrogen |
| COD | Chemical Oxygen Demand |
| HRT | Hydraulic Retention Time |
| R2A | Reasoner’s 2A Agar |
| CMC | Carboxymethyl Cellulose |
| NO3-N | Nitrate Nitrogen |
| DTN | Dissolved Total Nitrogen |
| RSM | Response Surface Methodology |
References
- Hasunuma, T.; Okazaki, F.; Okai, N.; Hara, K.Y.; Ishii, J.; Kondo, A. A review of enzymes and microbes for lignocellulosic biorefinery and the possibility of their application to consolidated bioprocessing technology. Bioresour. Technol. 2013, 135, 513–522. [Google Scholar] [CrossRef] [PubMed]
- Linkins, A.E.; Sinsabaugh, R.L.; McClaugherty, C.A.; Melills, J.M. Cellulase activity on decomposing leaf litter in microcosms. Plant Soil 1990, 123, 17–25. [Google Scholar] [CrossRef]
- Emsley, A.M. Cellulosic ethanol re-ignites the fire of cellulose degradation. Cellulose 2008, 15, 187–192. [Google Scholar] [CrossRef]
- Ugis, C.; Aiga, I. Recent developments in the sustainability of the production of polyurethane foams from polyols based on the first- to the fourth-generation of biomass feedstock. Curr. Opin. Green Sustain. Chem. 2023, 44, 100866. [Google Scholar] [CrossRef]
- Bhat, M.A.; Bhat, M.A.; Jan, S.; Shah, A.A.; Jan, A.T. Lignocellulosic biomass in circular economy: A techno-transition in carbon neutrality towards sustainable energy production. Biomass Bioenergy 2024, 189, 107349. [Google Scholar] [CrossRef]
- Zhong, Y.; Wang, T.; Yan, M.; Miao, C.; Zhou, X.; Tong, G. High-value utilization of bamboo pulp black liquor lignin: Preparation of silicon-carbide derived materials and its application. Int. J. Biol. Macromol. Struct. Funct. Interact. 2022, 217, 66–76. [Google Scholar] [CrossRef] [PubMed]
- Cai, C.; Jin, Y.; Pang, Y.; Ke, Q.; Qiu, W.; Qiu, X.; Qin, Y.; Lou, H. Tracing cellulase components in hydrolyzate during the enzymatic hydrolysis of corncob residue and its analysis. Bioresour. Technol. Rep. 2018, 4, 137–144. [Google Scholar] [CrossRef]
- Zhao, L.; Ma, Y.; Awasthi, M.K.; Tian, D.; He, J.; Huang, M.; Zou, J.; Lei, Y.; Shen, F. Enhancement of bacterial cellulose production synergistic H2 and volatile fatty acids from fruit and vegetable waste through retting pretreatment. Ind. Crops Prod. 2025, 225, 120554. [Google Scholar] [CrossRef]
- Zhao, G.; Wu, H.; Li, Y.; Huang, Z.; He, J.; Xie, X. Ensiling characteristics, in vitro digestibility and bacterial community structure of mulberry leaf silage with or without the addition of cellulase, protease, and starch. Front. Plant Sci. 2025, 16, 1517529. [Google Scholar] [CrossRef] [PubMed]
- Bogdanova, A.; Payuta, A.; Alekseev, A.; Konovalov, A. Influence of lactic acid and cellulolytic bacteria on the physicochemical parameters of alfalfa silage. IOP Conf. Ser. Earth Environ. Sci. 2021, 901, 012036. [Google Scholar] [CrossRef]
- Madhu, A.; Chakraborty, J. Covalent Immobilization of Cellulase Enzyme on Chitosan and Eudragit S-100 Biopolymers for Recovery and Reusability in Denim Fading Application. Fibers Polym. 2024, 25, 4557–4573. [Google Scholar] [CrossRef]
- Saira, O.; Vauhkonen, C. Cellulase-assisted refining in a paperboard mill: Avoided emissions from energy savings. A case study of a Finnish paperboard mill. Clean. Eng. Technol. 2024, 20, 100760. [Google Scholar] [CrossRef]
- Curiel, S.E.; Giráldez, A.; Pazos, M.; Sanromán, Á. From Waste to Resource: Valorization of Lignocellulosic Agri-Food Residues through Engineered Hydrochar and Biochar for Environmental and Clean Energy Applications—A Comprehensive Review. Foods 2023, 12, 3646. [Google Scholar] [CrossRef] [PubMed]
- Asifur, R.; Wei, W.; Divyapriya, G.; Seju, K.; Vikesland, P.J. Recent advances in environmental science and engineering applications of cellulose nanocomposites. Crit. Rev. Environ. Sci. Technol. 2023, 53, 650–675. [Google Scholar]
- Maki, M.; Leung, K.T.; Qin, W. The prospects of cellulase-producing bacteria for the bioconversion of lignocellulosic biomass. Int. J. Biol. Sci. 2009, 5, 500. [Google Scholar] [CrossRef] [PubMed]
- Xu, Z.; Dai, X.; Chai, X. Effect of different carbon sources on denitrification performance, microbial community structure and denitrification genes. Sci. Total Environ. 2018, 634, 195–204. [Google Scholar] [CrossRef] [PubMed]
- Kumar, R.; Singh, A.K. Effect of Multi-enzyme (Pectinase, Cellulase and Hemicellulase) Treatment on Clarification of Papaya (Carica papaya) Fruit Juice. Int. J. Recent Technol. Eng. 2019, 8, 12708–12721. [Google Scholar] [CrossRef]
- Zhang, S.; Wang, Z.; Shen, J.; Chen, X.; Zhang, J. Isolation of an Acidophilic Cellulolytic Bacterial Strain and Its Cellulase Production Characteristics. Agriculture 2023, 13, 1290. [Google Scholar] [CrossRef]
- Miao, Z.; Yufei, T.; Yajun, F.; Jing, G.; Yizhong, L.; Xiaofan, L.; Liying, G.; Jun, W. Nitrite accumulation, denitrification kinetic and microbial evolution in the partial denitrification process: The combined effects of carbon source and nitrate concentration. Bioresour. Technol. 2022, 361, 127604. [Google Scholar] [CrossRef] [PubMed]
- Chand, K.R.; Richa, S.; Hena, D.; Som, D.; Arvind, G. A rapid and easy method for the detection of microbial cellulases on agar plates using gram’s iodine. Curr. Microbiol. 2008, 57, 503–507. [Google Scholar] [CrossRef] [PubMed]
- Chukwuma, O.B.; Rafatullah, M.; Kapoor, R.T.; Tajarudin, H.A.; Ismail, N.; Alam, M.; Siddiqui, M.R. Optimization and comparative study of Bacillus consortia for cellulolytic potential and cellulase enzyme activity. Open Life Sci. 2025, 20, 20251066. [Google Scholar] [CrossRef] [PubMed]
- Marko, B.; Tea, S.; Anita, Š.; Marija, D.A.; Marina, T.; Mirela, P.; Bruno, Z. Standardization of 3,5-dinitrosalicylic acid (DNS) assay for measuring xylanase activity: Detecting and solving problems. Croat. J. Food Sci. Technol. 2023, 15, 151–162. [Google Scholar]
- Soledad, G.-G.; José, R.-J.; Feliciano, P.-C.; Dolores, L.d.C.M. Qualitative and quantitative sugar profiling in olive fruits, leaves, and stems by gas chromatography-tandem mass spectrometry (GC-MS/MS) after ultrasound-assisted leaching. J. Agric. Food Chem. 2010, 58, 12292–12299. [Google Scholar]
- Wang, X.; Huang, M.; Chen, S.; Bi, X.; Wang, L.; Tang, M.; Liu, Z.; Huang, Q.; Gao, S.; Maletskyi, Z. Alkalinity enhanced hydrolysis of primary sludge for carbon source recovery and its impact on denitrification in wastewater treatment. J. Environ. Manag. 2025, 373, 123903. [Google Scholar] [CrossRef] [PubMed]
- Li, Y.; Hu, R.; Yang, Z.; Huang, R.; Jiang, Y. Denitrification efficiency and accumulation characteristics of residual organics for the main compositions in woody biomass using a carbon source. J. Water Process Eng. 2025, 70, 106959. [Google Scholar] [CrossRef]

| Water Quality Index | NO3-N (mg/L) | TN (mg/L) | COD (mg/L) |
|---|---|---|---|
| Municipal Sewage | 31 | 43 | 80–100 |
| Level | ||||
|---|---|---|---|---|
| Factors | Symbols | −1 | 0 | 1 |
| Time/h | A | 48 | 96 | 144 |
| Temperature/°C | B | 35 | 40 | 45 |
| pH | C | 3 | 5 | 7 |
| Group | Carbon Source | Nitrogen Source | C/N | Bacterial Strain |
|---|---|---|---|---|
| 1 | maize straw | The nitrogen source used for all experimental groups was nitrate nitrogen. | 6/1 | D3-1 |
| 2 | maize straw | WH-01 | ||
| 3 | maize straw | D3-1 + WH-01 | ||
| 4 | MSFDL | D3-1 | ||
| 5 | MSFDL | WH-01 | ||
| 6 | MSFDL | D3-1 + WH-01 | ||
| 7 | glucose | D3-1 | ||
| 8 | glucose | WH-01 | ||
| 9 | glucose | D3-1 + WH-01 |
| Strain | Cellulase Activity (U/mL) | p-Value |
|---|---|---|
| N4-1 | 3.88 ± 0.06 | p = 0.18 |
| N1-1 | 4.37 ± 0.09 | p = 0.07 |
| N1-3 | 4.54 ± 0.13 | p = 0.06 |
| A1-1 | 4.57 ± 0.05 | p = 0.30 |
| D3-1 | 4.73 ± 0.08 | p = 0.11 |
| Run | (A) Time/h | (B) Temperature/°C | (C) pH | Cellulase Activity/(U/mL) |
|---|---|---|---|---|
| 1 | 48 | 35 | 5 | 8.35 |
| 2 | 144 | 35 | 5 | 6.68 |
| 3 | 48 | 45 | 5 | 12.67 |
| 4 | 144 | 45 | 5 | 10.04 |
| 5 | 48 | 40 | 3 | 9.21 |
| 6 | 144 | 40 | 3 | 9.05 |
| 7 | 48 | 40 | 7 | 9.75 |
| 8 | 144 | 40 | 7 | 7.04 |
| 9 | 96 | 35 | 3 | 9.4 |
| 10 | 96 | 45 | 3 | 12.30 |
| 11 | 96 | 35 | 7 | 8.84 |
| 12 | 96 | 45 | 7 | 12.34 |
| 13 | 96 | 40 | 5 | 16.30 |
| 14 | 96 | 40 | 5 | 16.30 |
| 15 | 96 | 40 | 5 | 16.30 |
| 16 | 96 | 40 | 5 | 16.30 |
| 17 | 96 | 40 | 5 | 16.30 |
| Source | Sum of Squares | df | Mean Square | F Value | p-Value |
|---|---|---|---|---|---|
| Model | 198.21 | 9 | 22.02 | 269.12 | <0.0001 |
| A-Time | 6.40 | 1 | 6.40 | 78.16 | <0.0001 |
| B-Temperature | 24.79 | 1 | 24.79 | 302.87 | <0.0001 |
| C-pH | 0.4932 | 1 | 0.4932 | 6.03 | 0.0438 |
| AB | 0.2066 | 1 | 0.2266 | 2.77 | 0.1401 |
| AC | 1.64 | 1 | 1.64 | 20.00 | 0.0029 |
| BC | 0.0889 | 1 | 0.0889 | 1.09 | 0.3320 |
| A2 | 82.01 | 1 | 82.01 | 1002.10 | <0.0001 |
| B2 | 25.36 | 1 | 25.36 | 309.92 | <0.0001 |
| C2 | 41.14 | 1 | 41.14 | 502.73 | <0.0001 |
| Residual | 0.5729 | 7 | 0.0818 | ||
| Lack of Fit | 0.5729 | 3 | 0.1910 | ||
| Pure Error | 0.0000 | 4 | 0.0000 | ||
| Cor Total | 198.79 | 16 | |||
| R-Squared | 0.9971 | ||||
| Adj. R-Squared | 0.9934 | ||||
| Pred. R-Squared | 0.9539 | ||||
| Adeq. Precision | 42.4843 |
| Detected Substance | 0 h (ug/mL) | 96 h (ug/mL) | Fold Change |
|---|---|---|---|
| Sucrose | 0.00225 | 0.00018 | 0.072 |
| D-Sorbitol | 0.00106 | 0.00042 | 0.396 |
| D-Arabinose | 0.00168 | 0.00052 | 0.309 |
| D-Fructose | 0.00395 | 0.00012 | 0.030 |
| D-Galactose | 0.00060 | 0.00039 | 0.65 |
| D-Galacturonic acid | 0.00041 | 0.00017 | 0.414 |
| Glucose | 0.00969 | 0.00015 | 0.015 |
| D-Glucuronic acid | 0.00031 | 0.00042 | 1.355 |
| Inositol | 0.01044 | 0.00043 | 0.041 |
| Levoglucosan | 0.00028 | 0.00037 | 1.321 |
| L-Rhamnose | 0.00028 | 0.00044 | 1.571 |
| D-Ribono-1,4-Lactone | 0.00003 | 0.00020 | 6.667 |
| D-Ribose | 0.00010 | 0.00049 | 4.9 |
| Raffinose | N/A | 0.00013 | >1 |
| Cellobiose | 0.00085 | 0.00033 | 0.388 |
| Phenylglucoside | 0.00014 | 0.00023 | 1.643 |
| Maltose | 0.02074 | 0.00016 | 0.008 |
| Trehalose | 0.00283 | 0.00032 | 0.113 |
| Xylitol | 0.00042 | 0.00049 | 1.167 |
| D-Arabinitol | 0.00287 | 0.00032 | 0.111 |
| D-Xylose | 0.00027 | 0.00036 | 1.333 |
| 1,5-Anhydroglucitol | 0.00030 | N/A | <1 |
| L-Fucose | 0.00016 | N/A | <1 |
| D-Mannose | 0.00086 | N/A | <1 |
| 2-Acetamido-2-deoxy-D-glucopyranose | 0.00051 | N/A | <1 |
Disclaimer/Publisher’s Note: The statements, opinions and data contained in all publications are solely those of the individual author(s) and contributor(s) and not of MDPI and/or the editor(s). MDPI and/or the editor(s) disclaim responsibility for any injury to people or property resulting from any ideas, methods, instructions or products referred to in the content. |
© 2025 by the authors. Licensee MDPI, Basel, Switzerland. This article is an open access article distributed under the terms and conditions of the Creative Commons Attribution (CC BY) license (https://creativecommons.org/licenses/by/4.0/).
Share and Cite
Shen, J.; Zhang, K.; Ren, Y.; Zhang, J. The Optimization of Culture Conditions for the Cellulase Production of a Thermostable Cellulose-Degrading Bacterial Strain and Its Application in Environmental Sewage Treatment. Water 2025, 17, 2225. https://doi.org/10.3390/w17152225
Shen J, Zhang K, Ren Y, Zhang J. The Optimization of Culture Conditions for the Cellulase Production of a Thermostable Cellulose-Degrading Bacterial Strain and Its Application in Environmental Sewage Treatment. Water. 2025; 17(15):2225. https://doi.org/10.3390/w17152225
Chicago/Turabian StyleShen, Jiong, Konglu Zhang, Yue Ren, and Juan Zhang. 2025. "The Optimization of Culture Conditions for the Cellulase Production of a Thermostable Cellulose-Degrading Bacterial Strain and Its Application in Environmental Sewage Treatment" Water 17, no. 15: 2225. https://doi.org/10.3390/w17152225
APA StyleShen, J., Zhang, K., Ren, Y., & Zhang, J. (2025). The Optimization of Culture Conditions for the Cellulase Production of a Thermostable Cellulose-Degrading Bacterial Strain and Its Application in Environmental Sewage Treatment. Water, 17(15), 2225. https://doi.org/10.3390/w17152225





